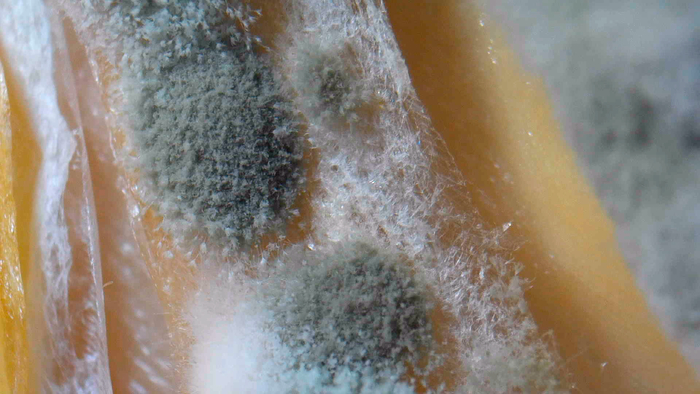
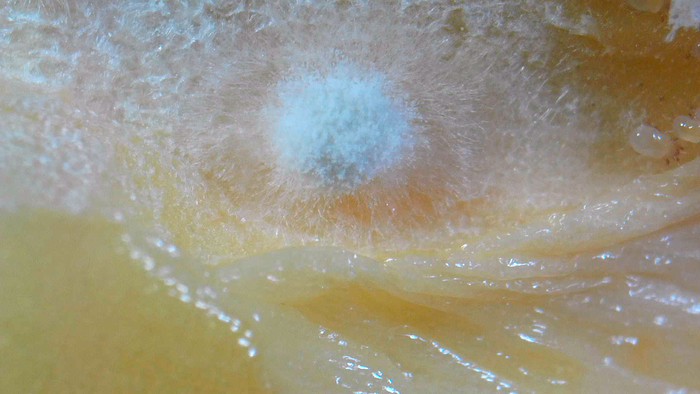

Микрофото. DC-DC повышающий преобразователь
Так как наш микроскоп, используемый для получения снимков, все же промышленный, то давайте посмотрим через него на электронику.
Сегодня у нас под объективом DC-DC повышающий модуль на базе микросхемы 2108А.
Модуль имеет размеры 11 х 10 мм.
На лицевой стороне модуля размещены: дроссель и диод.
На оборотной стороне: пара конденсаторов и сам DC-DC преобразователь.
Посмотрим на преобразователь в близи.
Взглянем на контакты модуля под максимальным увеличением.
Изучим диод Шоттки и его качество пайки под различными углами обзора.
Взглянем на дроссель.
Качество пайки конденсаторов.
Фото выполнены на промышленном микроскопе Andostar ADSM301.
Минимальное поле зрения - 7,5х4,2 мм, максимальное 20х12,5 мм.
Взят здесь: https://supereyes.ru/catalog/usb_microscope/adsm301_andonstar_hdmi_mikroskop/
DC-DC модуля, в наличии, такого же пока нет, но есть аналоги.
Брался здесь: https://supereyes.ru/catalog/dc_dc_povyshayushchie_preobrazovateli/
Получите скидку используя промокод - "OCTOBER".В комментариях Вы можете предложить свои объекты для будущих микроснимков.
Подписывайтесь, чтобы не пропустить новые посты.